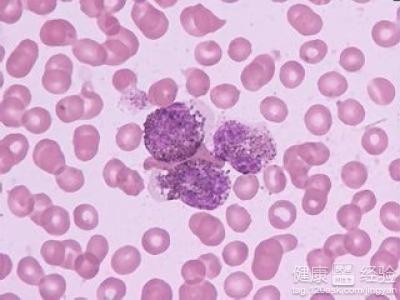
第1步

闌尾炎雖說只是一個小手術,一般不會有什麼問題,但是小手術也是手術,也是要動刀子的,所以對於老媽前段時間做闌尾炎手術我們全家是高度重視,尤其是術後護理聽說對恢復起著重要的作用,所以我們更是不敢大意,從飲食生活中時時注意,輪流侍候著,就怕一不小心傷口恢復不好。幸好一切如願,下面就和大家分享一下闌尾炎術後如何護理。
1患者的飲食方面在結構的定義來說應該是比較清淡才是適宜患者的,但是也要保證營養跟上。咖啡,濃茶這些就不要吃了,可以每天早上喝點小米粥,小米粥比較容易消化,對身體是比較好的,可以多喝一些。
2闌尾炎患者術後還要注意調整飲食,要少食多餐,多吃蔬菜、水果,少吃油炸的食物,因為油炸的食物可以誘發炎症,肉類可以少吃,但是不要過量,因為肉類在腸道內會被分解為好多毒素,不利於闌尾炎的康復。
3對於術後的病人來說,傷口崩線是件痛苦的事情,最好能平躺。術後病人應該吃有營養及容易消化的食物,多吃一些纖維食品,每天喝魚湯對傷口愈合很有好處,多吃水果或蔬菜。避免過度疲勞,因為恢復最少需要2-3個月

術後的一個月裡,這時候刀口處還比較脆弱,稍微不適,就會引起輕微陣痛,也盡量避免碰到水,最好是不要洗澡,剛開始的時候盡量不要去動它,隔些天可以去醫院復查刀口。
Copyright © 天天健康網 All Rights Reserved